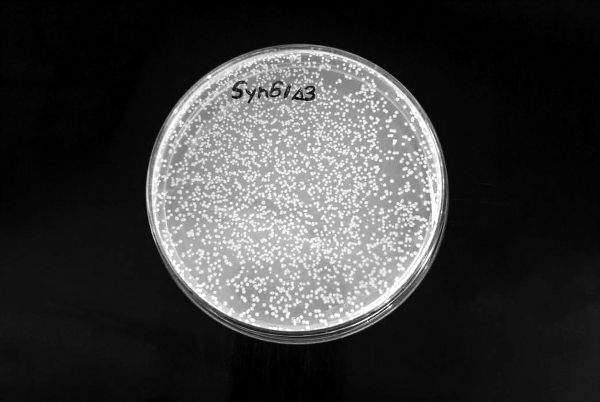

据西班牙《国家报》网站6月4日报道,英国一个科研团队创造了第一个对几乎所有病毒都具有抵抗力的生命形式。这是一种大肠杆菌,其基因组已经被改写,其中包括多达18000个基因变化,而这些变化迄今为止依然不存在于自然界当中。
报道称,大自然让人类能够自由行动、阅读、呼吸和思考,但也能启动病毒自我复制的恶性循环,进而引发如眼下这场新冠大流行一样的疫情。而对于微生物来说,大自然却使其能够产生避免机体感染病毒的方法。大自然创造人造生命形式的最大障碍之一在于,直到现在还不可能在“天然”蛋白质中引入实质性变化,而蛋白质分子对任何生命功能而言都是必不可少的。
报道指出,英国的科研团队发现,一个生物的遗传密码可以被深刻改变,从而创造出一个对任何病毒都具有免疫力的新物种。这项研究成果的重要性在于,地球上所有的生命形式都依赖于构成蛋白质的20种氨基酸。一个人的基因组含有大约30亿个碱基对,其中包括64个必不可少的基因序列——密码子。而这些密码子包含着合成这20种氨基酸的指令。
此项研究成果已经发表在美国《科学》周刊上。这个英国研究团队在研究报告中详细介绍了如何改写这些密码子的序列,使其具有两种惊人的功能。首先,这些密码子经过改写后能够创造新的人造氨基酸,这些新氨基酸直到现在还不存在于自然界中。其次,微生物基因组的改变对大多数噬菌体起到了“防火墙”的作用,因为这种改变能使几个密码子丧失功能,而病毒需要密码子来劫持细胞机制并开始自我复制。这一过程与新冠病毒感染人类的过程相同。
该研究团队认为,这一发现在研发新药和生物材料方面具有巨大潜力。大肠杆菌是一个真正的生物工厂,人类能利用其制造药物和发酵食物。大肠杆菌等微生物的变体被用于生产600多种药物,包括糖尿病患者的胰岛素和防止血栓的抗凝药物等。在这些变体中,有一种大肠杆菌对于制造针对新冠病毒的mRNA(信使核糖核酸)疫苗至关重要。
据报道,几年前,英国科学家已经证明了如何创造一种基因组水平上完全人造的微生物。如今他们已经能够使用一项技术在细菌的基因序列当中引入大规模变化。研究人员使用一种名为CRISPR-Cas9的基因编辑技术,像使用剪刀一样切割原始基因组的片段,随后再用先前在计算机中设计好的人工序列将其替换。
结果是惊人的:科学家向一组人造细菌释放了一种混合病毒,而这种病毒足以消灭任何天然的大肠杆菌。然而,人造细菌却安然无恙,并且生长得更迅速。这项研究也揭示出一个令人兴奋不已的事实:科学家改变了一个生物的原始遗传密码,而这个生物是数百万年自然进化而来的产物。
首个“百毒不侵”的人造大肠杆菌(英国“学术时报”网站)